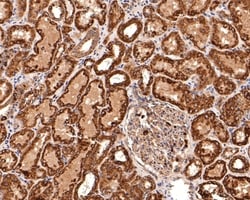
Invitrogen TIMM23 Polyclonal Antibody 100 &mu;L; Unconjugated:Antibodies,

missing translation for 'onlineSavingsMsg'
Learn More
Learn More
Invitrogen™ TIMM23 Polyclonal Antibody


Rabbit Polyclonal Antibody
Supplier: Invitrogen™ PA5144649
Description
Positive control: NIH/3T3 cell lysate, MCF-7 cell lysate, RAW264.7 cell lysate, A549 cell lysate, PC-12 cell lysate, rat testis tissue, human kidney tissue, mouse colon tissue. Predicted band size: 22 kDa Subcellular Location: Mitochondrion inner membrane.
Essential component of the TIM23 complex, a complex that mediates the translocation of transit peptide-containing proteins across the mitochondrial inner membrane.Identifiants chimiques
| TIMM23 | |
| Store at 4°C short term. For long term storage, store at -20°C, avoiding freeze/thaw cycles. | |
| Polyclonal | |
| Liquid | |
| IgG | |
| Human, Mouse, Rat | |
| Timm23 | |
| mitochondrial import inner membrane translocase subunit Tim23; TIM23; TIMM23; translocase of inner mitochondrial membrane 23; translocase of inner mitochondrial membrane 23 homolog; translocase of inner mitochondrial membrane 23 homolog (yeast); translocase of the inner mitochondrial membrane | |
| Timm23 | |
| Primary | |
| Affinity chromatography |
| 1 mg/mL | |
| Immunohistochemistry (Paraffin), Western Blot | |
| Unconjugated | |
| Rabbit | |
| RUO | |
| PBS with 0.1% BSA, 40% glycerol and 0.05% sodium azide; pH 7.4 | |
| O14925, O35093, Q9WTQ8 | |
| 100287932, 53600, 54312 | |
| Synthetic peptide within human TIMM23 aa 150-209. | |
| Antibody |
Spécifications
| TIMM23 | |
| Polyclonal | |
| Unconjugated | |
| Timm23 | |
| mitochondrial import inner membrane translocase subunit Tim23; TIM23; TIMM23; translocase of inner mitochondrial membrane 23; translocase of inner mitochondrial membrane 23 homolog; translocase of inner mitochondrial membrane 23 homolog (yeast); translocase of the inner mitochondrial membrane | |
| Rabbit | |
| Affinity chromatography | |
| RUO | |
| 100287932, 53600, 54312 | |
| Store at 4°C short term. For long term storage, store at -20°C, avoiding freeze/thaw cycles. | |
| Liquid |
| Immunohistochemistry (Paraffin), Western Blot | |
| 1 mg/mL | |
| PBS with 0.1% BSA, 40% glycerol and 0.05% sodium azide; pH 7.4 | |
| O14925, O35093, Q9WTQ8 | |
| Timm23 | |
| Synthetic peptide within human TIMM23 aa 150-209. | |
| 100 μL | |
| Primary | |
| Human, Mouse, Rat | |
| Antibody | |
| IgG |